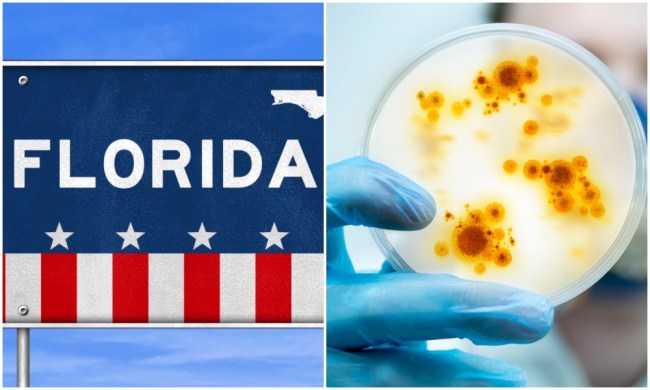

Getty/Istock
Florida has seen a major spike in positive tests for the coronavirus over the last week and counting and on Sunday reported a new record high of 15,300 new single-day positive tests. The state’s department of health also reported on Sunday that 11.25% of new cases tested positive, but it turns out that those numbers may be way off.
FOX 35 Orlando looked at the new astronomical numbers and instead of just accepting them, did a bit of digging of their own to see just how the positive numbers continue to shatter records.
According to their findings, “countless labs” around the state are actually reporting 100 percent positivity, which means every single person tested was positive.
**
Mark is an associate editor at BroBible. Follow him on Twitter @ItIsMarkHarris for the occasional good tweet. Feel free to contact him at Mark@BroBible.com.